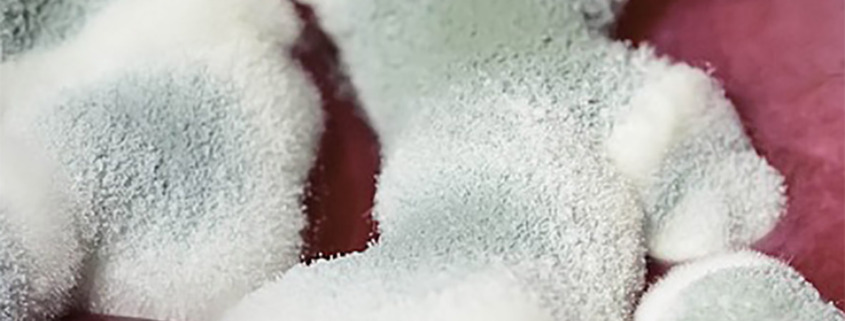

Protoplasma e Respirazione Primaria

Pubblico qui come una risorsa per tutti i lettori del blog il video del botanico W. Seifriz che nel 1950 effettuò una ricerca sul protoplasma di un tipo di muffa, video una volta rarissimo, ora per fortuna reso disponibile alla visione. Lo accompagna il commento di Franklyn Sills (da le Basi della Biodinamica Craniosacrale,pag 18).
sacrocraniale.wordpress.com/…/protoplasma-e-respirazione-primaria
A seguire, un altro contributo di una ricercatrice-artista, Heather Barnett, che crea con il Physarum polycephalum, un organismo eucariota che vive in zone fredde e umide, dal titolo “Cosa può imparare l’uomo da una muffa semi-intelligente”. Il video di H. Barnett è in inglese, ma si trova una versione sottotitolata in italiano a questo link https://www.ted.com/talks/heather_barnett_what_humans_can_learn_from_semi_intelligent_slime_1?language=it#t-2929